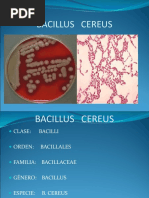

0% encontró este documento útil (0 votos)
35 vistas6 páginasPrevención de Gastroenteritis por Bacillus Cereus
Bacillus cereus es una bacteria que se encuentra en el suelo y que puede contaminar alimentos como arroz y papas. Esta bacteria puede causar dos tipos de intoxicaciones: la emética, que produce vómitos, y la diarreica. Para prevenir intoxicaciones por esta bacteria, los alimentos deben refrigerarse o cocinarse completamente y consumirse de inmediato, y se deben seguir buenas prácticas de higiene y almacenamiento para evitar su crecimiento.
Cargado por
doris vasquezDerechos de autor
© © All Rights Reserved
Nos tomamos en serio los derechos de los contenidos. Si sospechas que se trata de tu contenido, reclámalo aquí.
Formatos disponibles
Descarga como PDF, TXT o lee en línea desde Scribd
0% encontró este documento útil (0 votos)
35 vistas6 páginasPrevención de Gastroenteritis por Bacillus Cereus
Bacillus cereus es una bacteria que se encuentra en el suelo y que puede contaminar alimentos como arroz y papas. Esta bacteria puede causar dos tipos de intoxicaciones: la emética, que produce vómitos, y la diarreica. Para prevenir intoxicaciones por esta bacteria, los alimentos deben refrigerarse o cocinarse completamente y consumirse de inmediato, y se deben seguir buenas prácticas de higiene y almacenamiento para evitar su crecimiento.
Cargado por
doris vasquezDerechos de autor
© © All Rights Reserved
Nos tomamos en serio los derechos de los contenidos. Si sospechas que se trata de tu contenido, reclámalo aquí.
Formatos disponibles
Descarga como PDF, TXT o lee en línea desde Scribd